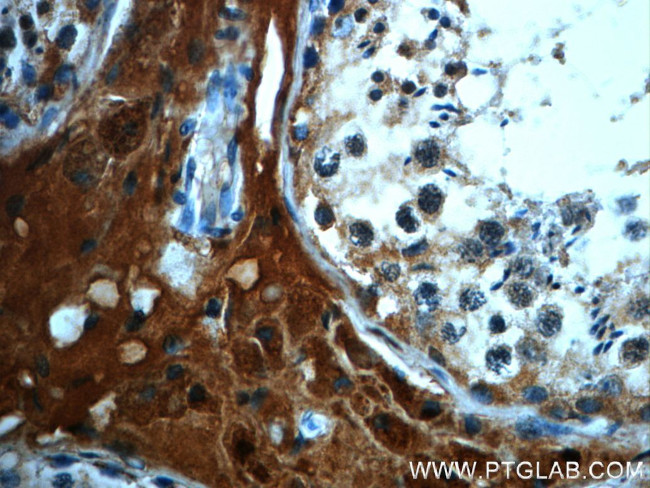
C4orf49 Antibody in Immunohistochemistry (Paraffin) (IHC (P))
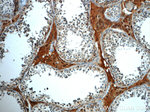
C4orf49 Antibody in Immunohistochemistry (Paraffin) (IHC (P))

Search
Proteintech
C4orf49 Polyclonal Antibody
{{$productOrderCtrl.translations['antibody.pdp.commerceCard.promotion.promotions']}}
{{$productOrderCtrl.translations['antibody.pdp.commerceCard.promotion.viewpromo']}}
{{$productOrderCtrl.translations['antibody.pdp.commerceCard.promotion.promocode']}}: {{promo.promoCode}} {{promo.promoTitle}} {{promo.promoDescription}}. {{$productOrderCtrl.translations['antibody.pdp.commerceCard.promotion.learnmore']}}
产品信息
22569-1-AP
种属反应
宿主/亚型
分类
类型
抗原
偶联物
形式
浓度
纯化类型
保存液
内含物
保存条件
运输条件
产品详细信息
Immunogen sequence: MYLRRAVSK TLALPLRAPP NPAPLGKDAS LRRMSSNRFP GSSGSNMIYY LVVGVTVSAG GYYAYKTVTS DQAKHTEHKT NLKEKTKAEI HPFQGEKENV AETEKASSEA PEELIVEAEV VDAEESPSAT VVVIKEASAC PGHVEAAPET TAVSAETGPE VTDAAARETT EVNPETTPEV TNAALDEAVT IDNDKDTTKN ETSDEYAELE EENSPAESES SAGDDLQEEA SVGSEAASAQ G (1-240 aa encoded by BC104174)
靶标信息
MGARP plays a role in the trafficking of mitochondria along microtubules. It regulates the kinesin-mediated axonal transport of mitochondria to nerve terminals along microtubules during hypoxia. It participates in the translocation of TRAK2/GRIF1 from the cytoplasm to the mitochondrion. It also plays a role in steroidogenesis through maintenance of mitochondrial abundance and morphology.
仅用于科研。不用于诊断过程。未经明确授权不得转售。
篇参考文献 (0)
生物信息学
蛋白别名: CESP-1; Corneal endothelium-specific protein 1; Hypoxia up-regulated mitochondrial movement regulator protein; Mitochondria-localized glutamic acid-rich protein; Ovary-specific acidic protein; Protein MGARP
基因别名: 4930583H14Rik; AI195347; C4orf49; CESP-1; CESP1; GS3582; HUMMR; MGARP; OSAP; Qsap
UniProt ID: (Human) Q8TDB4, (Mouse) Q8VI64
Entrez Gene ID: (Human) 84709, (Mouse) 67749